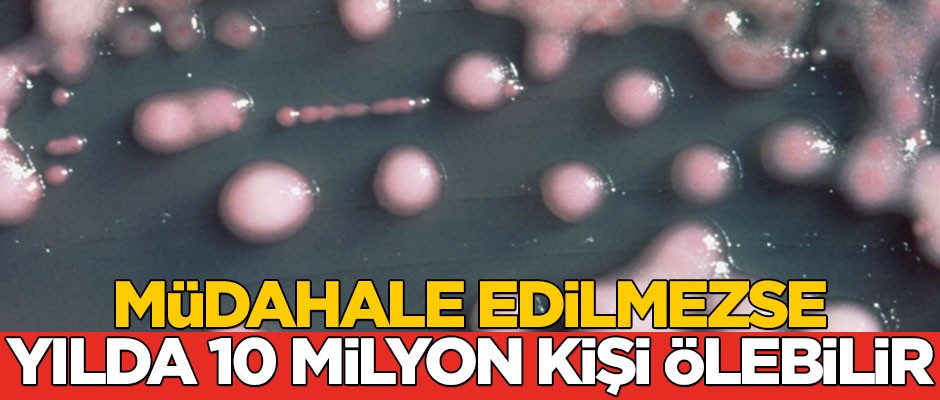
Arktik'te ortaya çıktı! Müdahale edilmezse yılda 10 milyon kişi ölebilir

Arktik'te ortaya çıktı! Müdahale edilmezse yılda 10 milyon kişi ölebilir
Dünya'nın kuzeyinde bulunan Arktik bölgesinde antibiyotiğe en dirençli bakteri bulundu. Keşfedilen bu bakterinin küresel sağlık önlemleri artırılmadığı sürece 2050 yılına kadar yılda 10 milyon kişiyi öldürebilecek seviyeye geleceği öngörülüyor
Kuzey Kutup Dairesi'nin üstünde kalan Arktik bölgesinde, insanlığın bu güne kadar keşfettiği ve antibiyotiğe en dirençli bakteri olarak bilinen bir 'superbug' (süper bakteri) bulundu.
İlk olarak Hindistan kökenli İsveçli bir hastanın 2008 yılında Delhi'ye yaptığı bir ziyaret sırasında Delhi'de tespit edilen 'The New Delhi Metallo-beta-lactamase-1 geni (blaNDM-1)' isimli bakteri, daha sonraları 2010'da Delhi sokaklarındaki yüzey suyunda da tespit edilmişti.
İnsan eliyle taşınmış olabilir
Aynı bakterinin, Norveç'in Kuzey Kutup Dairesi sınırında bulunan Svalbard topraklarında ortaya çıkarılması ise şaşkınlığa neden oldu. Söz konusu süper bakterinin, 12.870 kilometre uzaklıkta bulunan Delhi'den bu bölgeye nasıl geldiği bilinmiyor.
Ancak, öne çıkan ihtimaller arasında bakterinin göçmen kuşlar veya insanlar eliyle taşınması yer alıyor.
131 antibiyotiğe dirençli
Svalbard'daki sekiz bölgeden toplanan 40 toprak örneği üzerinden elde edilen bakterinin ayrıca, toplamda 131 antibiyotiğe dirençli olduğu tespit edildi.
Toplanan örneklerin yüzde 60'ından fazlasında bulunan ve incelemeye alınan bu dirençli bakteri ise insan sağlığı için ciddi tehlikeler barındırıyor.
"Tıbbi önlemleri alt edebilir"
Dünya Ekonomik Forumu'nda konuyla ilgili konuşan İngiltere Sağlık Bakanı Matt Hancock, "Antimikrobik direnç, insanlık için savaş veya iklim değişikliği kadar büyük bir tehlike oluşturuyor" ifadelerini kullandı.
Antibiyotik dirençli bakterilerin çoğalması ve yayılması halinde, ameliyatlar oldukça riskli hale gelebilir ve tehlike insanlığın tıbbi önlemlerini alt edebilecek seviyeye erişebilir. Konuyla ilgili olarak uluslararası bir strateji belirlenmediği, antibiyotik
kullanımı en azından kısmen azaltılamadığı ve özellikle gelişmekte olan ülkelerdeki küresel sağlık önlemleri artırılmadığı sürece, süper bakterilerin 2050 yılına kadar yılda 10 milyon kişiyi öldürebilecek seviyeye geleceği öngörülüyor.
"Aşırı antibiyorik kullanımı dirençli bakteriler meydana getirdi"
Bu tehlikenin meydana gelmesinde en çok etkili olan unsurlar ise, insanlarda gereksiz yere ve hayvanlarda aşırı antibiyotik kullanımı ve hijyen sorunu olarak sıralanıyor.
Svalbard'daki araştırma ekibine liderlik eden Newcastle Üniversitesi ekosistem mühendisliği profesörü David Graham, insanlığın karşı karşıya olduğu tehlikenin sebeplerine ilişkin şunları söyledi:
"İnsanların aşırı antibiyotik kullanımıyla yaptıkları şey, daha önce hiç bulunmayan dirençli bakteriler meydana getirmek oldu. Bölgesel stratejiler yeterli olmayacaktır, daha global düşünmeliyiz. Problem, politik hale gelecek."








